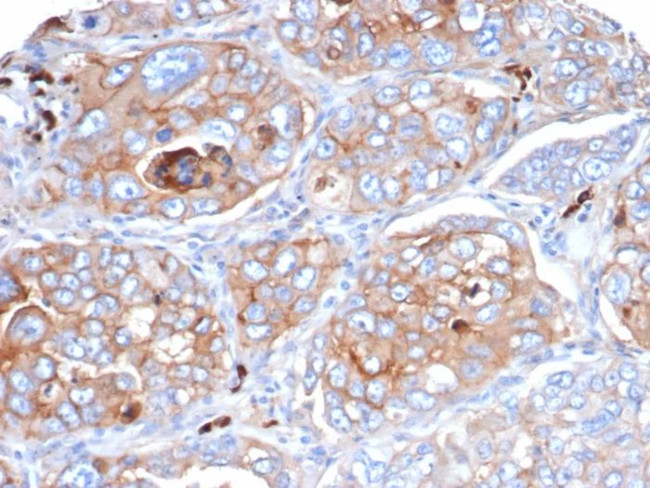
CD276/B7-H3 Antibody in Immunohistochemistry (Paraffin) (IHC (P))
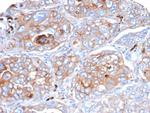
CD276/B7-H3 Antibody in Immunohistochemistry (Paraffin) (IHC (P))

Search
NeoBiotechnologies
CD276/B7-H3 Monoclonal Antibody (B7H3/4479)
{{$productOrderCtrl.translations['antibody.pdp.commerceCard.promotion.promotions']}}
{{$productOrderCtrl.translations['antibody.pdp.commerceCard.promotion.viewpromo']}}
{{$productOrderCtrl.translations['antibody.pdp.commerceCard.promotion.promocode']}}: {{promo.promoCode}} {{promo.promoTitle}} {{promo.promoDescription}}. {{$productOrderCtrl.translations['antibody.pdp.commerceCard.promotion.learnmore']}}
产品信息
80381-MSM9-P1
种属反应
宿主/亚型
分类
类型
克隆号
抗原
偶联物
形式
浓度
纯化类型
保存液
内含物
保存条件
运输条件
产品详细信息
Positive Control: hepatocellular carcinoma or lung carcinoma. Human tonsil Placenta
Cellular Location: Cytoplasm. Cell surface.
靶标信息
CD276 is a member of the B7 family of co-stimulatory molecules also known as B7-H3. CD276 is a type I transmembrane protein that induces the proliferation of CD4+ and CD8+ T cells, enhances the generation of cytotoxic T cells and selectively stimulates the production of interferon gamma. Expression of CD276 can be induced on dendritic cells and monocytes by inflammatory cytokines, and is also widely expressed in peripheral tissues including the heart, kidney, testis and colon. In humans, CD276 exists as two isoforms which result from gene duplication and differential splicing. CD276 is reported to have therapeutic potential for the regulation of cell-mediated immune responses to cancer, particularly in conjunction with anti-angiogenic therapy.
仅用于科研。不用于诊断过程。未经明确授权不得转售。
篇参考文献 (0)
生物信息学
蛋白别名: 4Ig-B7-H3; B7 homolog 3; B7-H3; CD276; CD276 antigen; Costimulatory molecule; sB7 H3; sB7H3; sCD276; soluble B7 H3; soluble B7H3; soluble CD276
基因别名: 4Ig-B7-H3; B7-H3; B7H3; B7RP-2; CD276; PSEC0249; UNQ309/PRO352
UniProt ID: (Human) Q5ZPR3
Entrez Gene ID: (Human) 80381